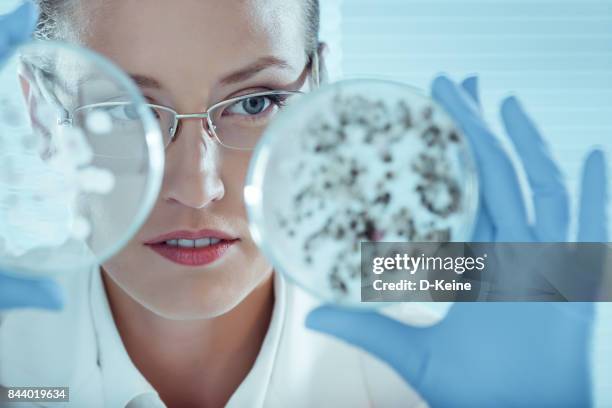

2017 Images
Sponsored by iStock
Get 15% off with StockEditor15
Royalty-free Images
194119 resultsAbout 2017 Images
Explore our curated collection of 2017 images. Whether you are looking for a desktop wallpaper, a website background, or social media content, you will find the highest quality assets here.
All photos are high-resolution and free for commercial use. Our library is updated daily with new photography.